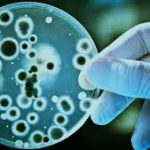
Biotechnology, application, Green Biotechnology, red biotechnology, White Biotechnology, Blue Biotechnology, BT cotton, Bacillus Thurinigiensis, ball worm, transgene, gene,

07 Mar 2019
Argon –The Element and Its Applications

Argon is the third most abundant gas on Earth. Incandescent bulbs and Compact Fluorescent Lamps (CFL) are two major light sources. Though, they apply two different methods for generation of light argon is employed in both bulbs. Incandescent bulb and compact fluorescent lamps – Role of argon Incandescent bulb produces light through thermal radiation. These
05 Mar 2019
International Women’s Day (IWD) Celebration on March 8

International Women’s Day (IWD) is celebrated on March 8 every year with the objective of raising awareness regarding the equality between genders and highlighting the importance of providing an opportunity for women in society. In many countries and societies, women were being sidelined or ignored when the matter of entrusting bigger roles arose. In many
21 Feb 2019
Transgenic Plants-Development And Advantages

Transgenic plant is one of the most important applications of biotechnology, which is the branch of science that refers to modification of living organism for useful purposes. In normal course, plants acquire genes through pollination. In a transgenic plant, one or more genes are artificially inserted to alter the characteristics of the plant and crop.
15 Feb 2019
Biotechnology and Its Applications
Biotechnology is made up of two words; ‘Bio’ means life and ‘Technology’ means application or harnessing of science for a specific purpose. Thus, biotechnology is the science of modifying or employing any living organism for a specific and useful purpose. Karoly Ereky, a Hungarian engineer, is believed to have coined the term in 1919. This
10 Feb 2019
Soma- The Injection Capsule That Should Be Swallowed

Soma is a drug capsule that can be swallowed by a person, which on reaching stomach will inject medicine to stomach wall. The test device is expected to be a substitute for injections. The device can be used to deliver oral doses of insulin by replacing the traditional injections through skin. At present, patients with
